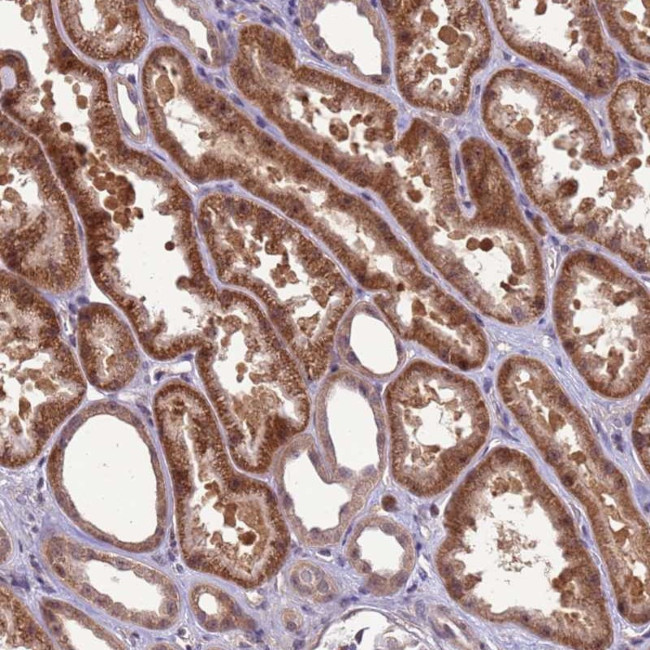
GEN1 Antibody in Immunohistochemistry (Paraffin) (IHC (P))

Search
Invitrogen
GEN1 Polyclonal Antibody
{{$productOrderCtrl.translations['antibody.pdp.commerceCard.promotion.promotions']}}
{{$productOrderCtrl.translations['antibody.pdp.commerceCard.promotion.viewpromo']}}
{{$productOrderCtrl.translations['antibody.pdp.commerceCard.promotion.promocode']}}: {{promo.promoCode}} {{promo.promoTitle}} {{promo.promoDescription}}. {{$productOrderCtrl.translations['antibody.pdp.commerceCard.promotion.learnmore']}}
产品信息
PA5-54335
种属反应
宿主/亚型
分类
类型
抗原
偶联物
形式
浓度
规格
纯化类型
保存液
内含物
保存条件
运输条件
RRID
产品详细信息
Immunogen sequence: LAIQQIKAVS KSLISESSQP NTSSHNISVI ADLHLSTIDW EGTSFSNSPA IQRNTFSHDL KSEVESELSA IPDGFENIPE QLSCESERYT ANIKKVLDED SDGISPEEHL LSGITDLCLQ DLPLKERIFI KLSYPQDNLQ PDVNLKT
Highest antigen sequence identity to the following orthologs: Mouse - 60%, Rat - 62%.
靶标信息
Xeroderma pigmentosum type G (XPG) is a human genetic disease exhibiting extreme sensitivity to sunlight. The XPG protein, a member of the flap endonuclease 1 (FEN-1) structure-specific DNA repair endonuclease family, is an enzyme essential for DNA repair of the major kinds of solar ultraviolet (UV)-induced DNA damages. Human XPG nuclease makes the 3' incision during nucleotide excision repair of DNA. The enzyme cleaves model DNA bubble structures specifically near the junction of unpaired DNA with a duplex region. A 29-amino acid region of human XPG (residues 981-1009) contains the PCNA binding activity. A conserved arginine in XPG (Arg992) is crucial for its PCNA binding activity. Replication Protein A (RPA) binds specifically and directly to two excision repair proteins, the xeroderma pigmentosum damage-recognition protein XPA and the endonuclease XPG.
仅用于科研。不用于诊断过程。未经明确授权不得转售。
篇参考文献 (0)
生物信息学
蛋白别名: Flap endonuclease GEN homolog 1; Gen endonuclease homolog 1; Holliday junction resolvase; unnamed protein product
基因别名: Gen; GEN1
UniProt ID: (Human) Q17RS7
Entrez Gene ID: (Human) 348654